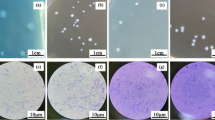

Abstract
The effects of two different parameters on the growth rate of L. casei and P. jensenii were discussed in this study. The impacts of glucose concentration 5, 10, 15, 18, 20 g/L) and incubation temperature (30, 35, 37, 40, 42 ℃) on the growth of both microorganisms in co-culture were investigated. The fermentation process was carried out for seven days in a 500 mL screw-capped bottle with 300 mL sterile MRS broth. The viable cell counts of bacteria, pH drops, and glucose concentration were analysed during the incubation period. The findings show that glucose concentration and incubation temperature had a significant impact on the production of the cell. The highest specific growth rate of L. casei and P. jensenii are 0.030/h and 0.041/h, respectively. Based on this study, the most suitable initial glucose concentration and incubation temperature for the fermentation of L. casei and P. jensenii in co-culture fermentation are 18 g/L and 37 ℃, respectively.
Access provided by Autonomous University of Puebla. Download conference paper PDF
Similar content being viewed by others
Keywords
- Co-culture fermentation
- Lactobacillus casei
- Propionibacterium jensenii
- The effect of glucose
- Incubation temperature
1 Introduction
Probiotics are feed supplement of live microorganism that will confer beneficial effects to the host [1, 2]. The U.S. Food and Drug Administration (FDA) refer to these live microorganisms as direct-fed microbial in animal feeds. This term is suitable for animal feed as the definition given a narrower application as microbial-based feed additives [3]. From the descriptions given by Fuller [1] and FAO/WHO [2], the live microorganisms must be viable during storage and consumptions. In addition, the concentration of the direct-fed microbial must be adequate in the range of 7 and 8 log CFU/mL upon consumption [4]. Direct-fed microbial must be non-pathogenic, technologically suitable for industrial processes, resistant to acid and bile, capable of producing antimicrobial substances, modulating immune responses, and influential to the gut’s activities. However, Applegate et al. [5] stated that the stringent considerations of direct-fed microbial attributes could not be achieved using only a single strain.
Co-culture is defined by Bader et al. [6] as incubation of anaerobic or aerobic of different specified microbial strains under aseptic conditions. Co-culture fermentation offered efficient carbon utilisation in the presence of lignocellulose (substrates) [7], improved the growth and survival populations, and subsequently increased the biomass yield [8]. Hence, a co-culture system proposed a satisfactory compromise in developing direct-fed microbial due to its capability to achieve the desired aspect of microbiological, technological performance promoting, and registration capabilities of the strains tested.
Lactobacillus and Propionibacterium are commonly utilised in co-culture fermentation. Both species have found their usage in various co-culture processes with different microorganisms to produce various substances or products. Lactobacillus sp., one of the lactic acid bacteria (LAB), is often co-incubated with the microorganisms such as Saccharomyces sp., Bifidobacterium sp., Aspergillus sp., Bacillus sp., and Propionibacterium sp. Propionibacterium sp., also known as propionic acid bacteria (PAB), is co-incubated with other species such as Streptococcus sp., Lactococcus sp., Bifidobacterium sp., and Veillonella sp. Both species can be found used in probiotics production, food and beverages production, microbial chemical and organic acid production, antimicrobial substances and others such as natural folate and vitamin B12.
Hugenschmidt et al. [9] reported that the co-cultivation of LAB and PAB species have a stimulatory effect on the growth rate of the cultures and metabolic dependency between two species, as LAB species produce lactate and PAB species use this. This effect is because lactate is much more preferred than sugars by PAB. Wu et al. [10] reported that the co-culture fermentation of Bifidobacterium sp. (LAB bacterium) with Propionibacterium freudenreichii increased the growth and survival of Bifidobacterium sp. To six times compared to its mono-culture growth and survival in the same medium. The same result was reported by Ranadheera et al. [11], significant growth and survival of L. acidophilus co-culture with P. jensenii during storage at 4 ℃ was observed.
In this study, a co-culture fermentation of L. casei and P. jensenii was carried out at various glucose concentration and incubation temperature to evaluate each microbes’ cell growth in co-culture, pH reduction and glucose consumption.
2 Material and Methods
2.1 Microorganism
The microorganisms used in this study were bought from American Type Cell Culture (ATCC Virginia, USA). The species used in this study were Lactobacillus casei ATCC 393 and Propionibacterium jensenii ATCC 4871.
2.2 Fermentation Conditions
Co-culture fermentations were carried out in MRS (de Man Rogosa and Sharpe) broth. The fermentation medium was prepared as follows 10.0 g peptone from casein, 8.0 g meat extract, 4.0 g yeast extract, 2.0 g di-potassium hydrogen phosphate, 1.0 g TWEEN® 80, 2.0 g di-ammonium hydrogen citrate, 5.0 g sodium acetate, 0.2 g magnesium sulphate and 0.04 g manganese sulphate) were added into one-litre distilled water with the concentration for glucose was varied accordingly.
The effect of glucose concentration on co-culture fermentation was investigated by fermentation at various glucose concentrations ranging from 5 to 20 g/L. The medium was inoculated with L. casei and P. jensenii at 1:4 (% v/v) inoculum ratio, respectively. Fermentation was carried out statically at 30 ℃ for 120 h. The samples were collected at 0, 3, 6, 9, 12, 24, 48, 72, 96 and 120 h. These samples were then analysed for viable cells of L. casei and P. jensenii, pH and glucose concentration.
Selected glucose concentration then was used to study the effect of incubation temperature on co-culture fermentation. The same inoculation ratio was used. The fermentation was carried out at five different incubation temperatures, 30, 35, 37, 40 and 42 ℃ The samples were collected at 0, 3, 6, 9, 12, 24, 48, 72, 96 and 120 h. These samples were then analysed for viable cells of L. casei and P. jensenii, pH and glucose concentration.
2.3 Enumeration of Viable Cell
The enumerations of the viable cell for both microbes were carried out using the spread plate method. 100 µL from serial decimal dilutions were plated on each suitable agar, MRS agar for L. casei, while sodium lactate agar (SLA) for P. jensenii. The plates with visible colonies in the range of 30–300 colonies were calculated and recorded as colony-forming units per millilitre (CFU/mL). MRS agar was prepared by mixing 68.2 g of MRS agar (Merck) with one litre of distilled water. SLA agar was prepared by adding 10 g of enzymatic digest of casein, 10 g of yeast extract, 2.5 g potassium phosphate monobasic, 16.67 g of sodium lactate, 0.005 g of magnesium sulphate and 15 g agar into one litre of distilled water. Both agars were heated until boiled before autoclaved. Afterwards, the agars were poured into the petri dishes inside a safety cabinet to avoid contamination on the agar.
2.4 Measurement of pH and Glucose Concentration
The pH of the culture was directly measured using a pH metre at room temperature. The determination of total sugar consumption by L. casei and P. jensenii in co-culture fermentation was carried out using the 3,5-dinotrosalicyclic acid (DNS) method. First, one millilitre culture and one millilitre distilled water were pipetted into two different test tube. Then, 2 mL DNS was added into the test tubes, and the mixture was thoroughly mixed before heated at 90 ℃ for 5 min. Afterwards, the mixture was cooled down, and 7 mL of distilled water was added. Then the absorbance was measured at 540 nm.
3 Result and Discussion
3.1 The Effect of Glucose Concentration on the Growth of L. casei and P. jensenii and pH Changes During Co-culture Fermentation
As glucose was the primary carbon source used in this study, different initial glucose concentrations were varied in the range of 5 and 20 g/L. The initial population of L. casei and P. jensenii was 7.77 and 6.62 log CFU/mL. The growth of L. casei and P. jensenii during co-culture fermentation in five different glucose concentrations are shown in Fig. 1. At the same time, the pH changes of the co-culture in different glucose concentrations are shown in Fig. 2.
The increase in numbers of cell density was measured from time to time, and a growth curve was plotted. Several distinct growth phases can be observed in Fig. 1: exponential, stationary, and death phase. Figure 1 shows the unnoticeable lag phase due to the cell’s ability to adjust rapidly with the environment resulting in a shorter lag phase. At the time the second sampling was taken, the cell already reached its exponential phase. Each microbe's specific growth rate in different glucose concentrations was calculated from the growth curve and tabulated in Table 1.
The optimum glucose concentration for the growth of co-culture fermentation was found at a glucose concentration of 18 g/L, with a specific growth rate for L. casei and P. jensenii was 0.021 h−1. Although the specific growth rate of P. jensenii was higher at a glucose concentration of 20 g/L, the specific growth rate of L. casei was lower than at 18 g/L. Table 1 shows that the growth rate of L. casei reached its optimum at 18 g/L but decreasing at a glucose concentration higher than that. However, in P. jensenii case, the growth rate increased as the glucose concentration increased. This result can be supported by the outcomes of the study made by Khosravi-Darani and Zoghi [12], which reported an increase in yield and productivity of fermentation products at 18% w/w.
The pH changes for different initial glucose concentrations were recorded for 120 h and shown in Fig. 2. The initial pH of the medium was adjusted to 7.0 before the fermentation. pH changes during the fermentation of Lactobacillus sp. and Propionibacterium sp. indicating that organic acid was being produced. The lowest pH recorded at the end of 120 h fermentation was 4.44 for glucose concentration of 18 and 20 g/L. A sharp decrease in pH can be observed for glucose concentration of 10 g/L. At the glucose concentration of 5 g/L, pH culture at the end of 120 h incubation time did not reach below 5 compared to other batches with higher glucose concentration. This is probably due to the limited glucose supply available in the medium.
3.2 The Effect of Incubation Temperature on the Growth of L. casei and P. jensenii and pH Changes During Co-culture Fermentation
Five different incubation temperatures, 30, 35, 37, 40 and 42 ℃, were studied. The initial cell concentrations were kept the same as during the study of glucose concentration, while the initial glucose concentration was at 18 g/L. The growth of L. casei and P. jensenii during co-culture in five different incubations temperature is shown in Fig. 3. At the same time, the pH changes of the co-culture in different incubation temperature are depicted in Fig. 4. The specific growth rate of each species incubated at different temperature was calculated from the growth curve and tabulated in Table 2.
As seen in Fig. 3, the highest viability of cell obtained was 9.62 log CFU/mL for L. casei and 8.48 log CFU/mL for P. jensenii at an incubation temperature of 37 ℃. The specific growth rates for both species were the highest at 37 ℃ with 0.030 h−1 and 0.041 h−1 for L. casei and P. jensenii, respectively, as depicted in Table 2. The specific growth rate for L. casei and P. jensenii were the lowest at a temperature higher than 40 ℃, 0.017 h−1 and 0.019 h−1 for L. casei and P. jensenii, respectively. The decrease in growth rate might be probably due to the decreasing activity of cellular enzymes. These enzymes are most active at the optimum temperature, thus directly affect the growth rate of cells [13].
This study shows that 37 ℃ was suitable for obtaining high viability cells for both L. casei and P. jensenii. This finding is per the previous study by Patrick and McDowell [14], for the optimum growth of Propionibacterium sp. was recorded between 30 and 37 ℃, and the optimum growth of L. casei in pumpkin waste was reported at 37 ℃ [15]. The findings might be varied because the value of the controlled parameters was different, and the microbes used were not the same. This different result might be because of the different conditions of the co-culture and the inoculation ratio of the two species.
The pH changes for 120 h incubated in different incubation temperatures were recorded and shown in Fig. 4. There were no significant differences in pH changes in all the batches except during incubation at 30 ℃ which showed a gradual decrease in pH value. This observation is probably due to the growth rate of cell that affected by incubation temperature. As organic acid production is related to the growth of the cell, slow growth of the cell indicates slow production of organic acid. The pH culture at the end of the fermentation was recorded at 4.35.
4 Conclusion
In general, this study was conducted to investigate the effect of glucose concentration and incubation temperature on the growth of L. casei and P. jensenii in co-culture fermentation. At the end of this study, the effect of different value of glucose concentration and incubation temperature on the growth rate of L. casei and P. jensenii has been determined. According to the results of this study, the highest specific growth rate of L. casei and P. jensenii was 0.030 h−1 and 0.041 h−1, respectively, in glucose concentration of 18 g/L and incubation temperature of 37 ℃.
References
Fuller, R.: Probiotics in man and animals. J. Appl. Bacteriol. 66, 1365–1378 (1989). https://doi.org/10.1111/j.1365-2672.1989.tb05105.x
FAO/WHO: Evaluation of health and nutritional properties of probiotics in food including powder milk with live lactic acid bacteria. Report of a Joint FAO/WHO Expert Consultation. Córdoba, Argentina (2001)
Seo, J.K., Kim, A.W., Kim, M, H.: Direct-fed microbials for ruminant animals. Asian-Australasian J. Anim. Sci. 23:1657–1667 (2010). https://doi.org/10.5713/ajas.2010.r.08
Makinen, K., Nerger, B., Bel-Rhlid, R., Anaanta, E.: Science and technology for the mastership of probiotic applications in food products. J. Biotechnol. 162, 356–365 (2012). https://doi.org/10.1016/j.jbiotec.2012.07.006
Applegate, T.J., Klose, V., Steiner, T., Ganner, A., Schatzmayr, G.: Probiotics and phytogenics for poultry: myth or reality? In: Informal Nutrition Symposium at the Poultry Science Association’s 98th annual meeting in Raleigh, North Carolina, 20–23 July (2009)
Bader, J., Mast-Gerlach, E., Popović, K., Bajpai, R., Stahl, U.: Relevance of microbial co-culture fermentations in biotechnology. J. Appl. Microbiol. 109, 371–387 (2010)
Tesfaw, A., Assefa, F.: Co-culture: A great promising method in single cell protein production. Biotechnol. Mol. Biol. Rev. 9(2), 12–20 (2014)
Aghababaie, M., Khanahmadi, M., Beheshti, M.: Developing a kinetic model for co-culture of yogurt starter bacteria growth in pH controlled batch fermentation. J. Food Eng. 166, 72–79 (2015)
Hugenschmidt, S., Schwenninger, S.M., Lacroix, C.: Concurrent high production of natural folate and vitamin B12 using a co-culture process with Lactobacillus plantarum SM39 and Propionibacterium freudenreichii DF13. Process Biochem. 46, 1063–1070 (2011). https://doi.org/10.1016/j.procbio.2011.01.021
Wu, Q.Q., You, H.J., Ahn, H.J., Kwon, B., Ji, G.E.: Changes in growth and survival of Bifidobacterium by co-culture with Propionibacterium in soy milk, cow’s milk, and modified MRS medium. Int. J. Food Microbiol. 157, 65–72 (2012)
Ranadheera, C.S., Evans, C.A., Adams, M., Baines, S.K.: Co-culturing of probiotics influences the microbial and physico-chemical properties but not sensory quality of fermented dairy drink made from goats’ milk. Small Rumin. Res. 136, 104–108 (2016)
Khosravi-Darani, K., Zoghi, A.: Comparison of pretreatment strategies of sugarcane baggase: Experimental design for citric acid production. Biores. Technol. 999150, 6986–6993 (2008)
Panesar, P.S., Kennedy, J.F., Knill, C,J., Kosseva, M.: Production of L(+) lactic acid using Lactobacillus casei from Whey. Brazilian Arch. Biol. Technol. 53, 219–226 (2010). https://doi.org/10.1590/S1516-89132010000100027
Patrick, S., McDowell, A.: Genus I. Propionibacterium Orla-Jensen 1909. In: Goodfellow, M., Kämpfer, P., Busse, H.-J., Trujillo, M.E., Suzuki, K., Ludwig, W., William B, W. (eds.) Bergey’s Manual of Systematic Bacteriology vol. 5, 2nd edn., pp. 1138–1188. Springer New York Dordrecht Heidelberg London, Athens, USA (2012)
Genevois, C., Flores, S., de Escalada Pla, M.: Byproduct from pumpkin (Cucurbita moschata Duchesne ex poiret) as a substrate and vegetable matrix to contain Lactobacillus casei. J. Funct. Foods. 23, 210–219 (2016). https://doi.org/10.1016/j.jff.2016.02.030
Acknowledgements
The authors would like to express their appreciation to Universiti Teknologi Malaysia for the support under the UTM Fundamental Research grant with Project No. 21H31.
Author information
Authors and Affiliations
Corresponding author
Editor information
Editors and Affiliations
Rights and permissions
Copyright information
© 2021 The Author(s), under exclusive license to Springer Nature Singapore Pte Ltd.
About this paper
Cite this paper
Mohamed Esivan, S.M., Rashid, R., Jati, A., Zaharudin, N.A. (2021). Growth of Lactobacillus casei and Propionibacterium jensenii in Different Glucose Concentration and Incubation Temperature. In: Abdul Karim, S.A., Abd Shukur, M.F., Fai Kait, C., Soleimani, H., Sakidin, H. (eds) Proceedings of the 6th International Conference on Fundamental and Applied Sciences. Springer Proceedings in Complexity. Springer, Singapore. https://doi.org/10.1007/978-981-16-4513-6_9
Download citation
DOI: https://doi.org/10.1007/978-981-16-4513-6_9
Published:
Publisher Name: Springer, Singapore
Print ISBN: 978-981-16-4512-9
Online ISBN: 978-981-16-4513-6
eBook Packages: Physics and AstronomyPhysics and Astronomy (R0)